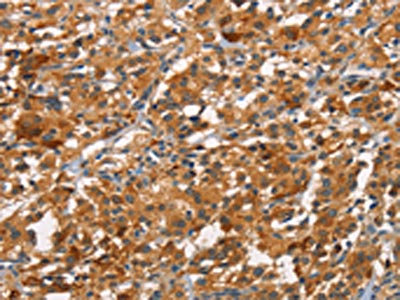

CDC25B Antibody
-
中文名稱:CDC25B兔多克隆抗體
-
貨號:CSB-PA786395
-
規(guī)格:¥1100
-
圖片:
-
The image on the left is immunohistochemistry of paraffin-embedded Human thyroid cancer tissue using CSB-PA786395(CDC25B Antibody) at dilution 1/45, on the right is treated with synthetic peptide. (Original magnification: ×200)
-
The image on the left is immunohistochemistry of paraffin-embedded Human brain tissue using CSB-PA786395(CDC25B Antibody) at dilution 1/45, on the right is treated with synthetic peptide. (Original magnification: ×200)
-
-
其他:
產(chǎn)品詳情
-
Uniprot No.:
-
基因名:
-
別名:AI604853 antibody; Cdc 25B antibody; Cdc25b antibody; CDC25HU2 antibody; Cdc25m2 antibody; Cell division cycle 25 homolog B antibody; Cell division cycle 25B antibody; Cell division cycle 25B isoform 1 antibody; Cell division cycle 25B isoform 2 antibody; Cell division cycle 25B isoform 3 antibody; Cell division cycle 25B isoform 4 antibody; Cell division cycle 25B isoform 5 antibody; Dual specificity phosphatase Cdc25B antibody; EC 3.1.3.48 antibody; M phase inducer phosphatase 2 antibody; M-phase inducer phosphatase 2 antibody; MPIP2_HUMAN antibody
-
宿主:Rabbit
-
反應(yīng)種屬:Human
-
免疫原:Synthetic peptide of Human CDC25B
-
免疫原種屬:Homo sapiens (Human)
-
標(biāo)記方式:Non-conjugated
-
抗體亞型:IgG
-
純化方式:Antigen affinity purification
-
濃度:It differs from different batches. Please contact us to confirm it.
-
保存緩沖液:-20°C, pH7.4 PBS, 0.05% NaN3, 40% Glycerol
-
產(chǎn)品提供形式:Liquid
-
應(yīng)用范圍:ELISA,IHC
-
推薦稀釋比:
Application Recommended Dilution ELISA 1:2000-1:5000 IHC 1:50-1:200 -
Protocols:
-
儲存條件:Upon receipt, store at -20°C or -80°C. Avoid repeated freeze.
-
貨期:Basically, we can dispatch the products out in 1-3 working days after receiving your orders. Delivery time maybe differs from different purchasing way or location, please kindly consult your local distributors for specific delivery time.
-
用途:For Research Use Only. Not for use in diagnostic or therapeutic procedures.
相關(guān)產(chǎn)品
靶點詳情
-
功能:Tyrosine protein phosphatase which functions as a dosage-dependent inducer of mitotic progression. Required for G2/M phases of the cell cycle progression and abscission during cytokinesis in a ECT2-dependent manner. Directly dephosphorylates CDK1 and stimulates its kinase activity. The three isoforms seem to have a different level of activity.
-
基因功能參考文獻:
- miR-152 was a tumor suppressor in EC that inhibited proliferation of human endometrial cancer cells via inducing G2/M phase arrest by suppressing CDC25B expression. PMID: 29353204
- High CDC25B expression is associated with non-small cell lung cancer metastasis. PMID: 28656293
- YWHAE silencing induces cell proliferation, invasion and migration through the up-regulation of CDC25B and MYC in gastric cancer cells. PMID: 27863420
- While the low expression level of DUSP7 was restricted to patients with positive rheumatoid factor and anti-citrullinated protein antibodies, the altered expression of CDC25B correlated with the activity of early arthritis. PMID: 28253537
- Conformational flexibility of the complete catalytic domain of Cdc25B phosphatase has been demonstrated. PMID: 27410025
- High CDC25B expression is associated with esophageal carcinoma. PMID: 25775393
- Solution NMR studies reveal no global flexibility in the structure of CDC25b catalytic domain PMID: 24740794
- For the first time, we demonstrate that miRNA-211 is a direct negative regulator of CDC25B expression in TNBC cells, alters other related target proteins CCNB1 and FOXM1, and then inhibits breast cancer cells growth, migration, and invasion PMID: 25680404
- FK-3000 exerts its antiproliferative effect through G2/M cell cycle arrest via downregulation of cyclin B and phospho-CDC2 by p38 MAPK phosphorylation and CDC25B dephosphorylation . PMID: 25384584
- RSK promotes G2/M transition in mammalian cells through activating phosphorylation of Cdc25A and Cdc25B. PMID: 23708659
- Cdc25B upregulation and 14-3-3sigma downregulation might promote development of bladder cancer and suggested a poor prognosis. PMID: 24234332
- Positive expression of CDC25B in astrocytoma affects the prognosis in an adverse manner. PMID: 24344030
- CDC25B is a pro-influenza A virus host factor. PMID: 24109234
- CDC25B, through activation of a centrosomal pool of CDK2, stabilises the local pool of Mps1 which in turn regulates the level of centrin 2 at the centrosome. PMID: 23840880
- Phosphorylation and inhibition of cdc25B causes delayed progression from G2 into mitosis in melanoma cells. PMID: 23908401
- Indirubin, an acting component of indigo naturalis, inhibits EGFR activation and EGF-induced CDC25B gene expression in epidermal ke PMID: 22721997
- downregulation of Cdc25B resulted in slower growth, more G2/M cells, weaker capacity for migration and invasion and induction of apoptosis in renal carcinoma cell line 769-P transfectants; findings suggest an important role of Cdc25B in renal cell carcinoma development PMID: 22631674
- Transcriptional repression mediated by IER5 regulates Cdc25B expression levels via the release of NF-YB and p300 in acute myeloid leukemia. PMID: 22132193
- We identified CDC25B as novel miR-148a target which may confer a proliferative advantage in pancreatic ductal adenocarcinomas. PMID: 21709669
- Ser169 phosphorylation can disrupt 14-3-3 binding to Ser151 activating Cdc25B3, providing a mechanism for regulating Cdc25B3 activation without dephosphorylation of the 14-3-3 binding sites. PMID: 21558810
- there are 13 sites phosphorylated by PLK1 in CDC25B.This study illustrates the complexity of the phosphorylation pattern and of the subsequent regulation of CDC25B activity. PMID: 21640712
- Deletion and mutation analyses of the Cdc25B promoter revealed that downregulation by p53 is dependent on the presence of functional Sp1/Sp3 and NF-Y binding sites PMID: 21242964
- CDC25B forms a close association with Ctn-2 proteins at the centrosome. PMID: 21091437
- Our findings reveal the existence of a previously unrecognized CDC25B isoform that operates specifically in the nucleus to reinitiate G2/M transition after DNA damage PMID: 21363925
- The mitotic phosphorylation of Ser(321) acts to maintain full activation of Cdc25B by disrupting 14-3-3 binding to Ser(323) and enhancing the dephosphorylation of Ser(323) to block 14-3-3 binding to this site. PMID: 20801879
- CDC25B a minor role in the pathogenesis and/or progression of vulvar squamous cell carcinomas. PMID: 20500813
- A moderate and unscheduled increase in CDC25B level, as observed in a number of human tumours, is sufficient to overcome the S-phase checkpoint efficiency thus leading to replicative stress and genomic instability. PMID: 20128929
- A new mechanism of CDC25B regulation in response to stress. PMID: 20176018
- Adventitious arsenate reductase activity of the catalytic domain of the human Cdc25B phosphatases. PMID: 20025242
- nuclear localization and serine 146 integrity required for induction of mitosis PMID: 12107172
- pEg3 kinase is able to specifically phosphorylate CDC25B in vitro. One phosphorylation site was identified and corresponded to serine 323 PMID: 12400006
- we demonstrate that phosphorylation of CDC25B by protein kinase CK2 increases the catalytic activity of the phosphatase in vitro as well as in vivo.CDC25B interacts with CK2, and this interaction, mediated by the CK2beta regulatory subunit PMID: 12527891
- upregulation of Cdc25B in human prostate cancer and its interplay with androgen receptor may contribute to prostate cancer development PMID: 12569365
- Data show that FHL3 (human four-and-a-half LIM-only protein 3) interacts with human phosphatase CDC25B in the cell nucleus. PMID: 12681290
- Cdc25B may play important roles in the development and progression of endometrioid endometrial carcinoma and clear cell carcinoma and uterine pappillary serous carcinoma by different mechanism. PMID: 14559803
- cdc25B plays a role in the early phase of thyroid lymphoma possibly including the malignant transformation from chronic thyroiditis PMID: 14767575
- Identification of a nuclear export signal in CDC25B. PMID: 15003534
- Phosphorylation of CDC25B by AURA at the centrosome contributes to the G2-M transition. PMID: 15128871
- 14-3-3 subtypes can control the subcellular localization of CDC25B by binding to a specific site. PMID: 15173315
- Cdc25B localisation and nuclear export changes during the cell cycle and in response to stress PMID: 15456846
- Results suggest that cdc25B is important especially in the early phase of breast carcinoma progression. PMID: 15550849
- These results support a model in which pEg3 contributes to the control of progression through mitosis by phosphorylation of the CDC25 phosphatases. PMID: 15908796
- Aurora-A-mediated phosphorylation of CDC25B at the centrosome is an important step contributing to the earliest events inducing mitosis, upstream of CDK1-cyclin B1 activation PMID: 16082213
- MAPKAP kinase-2 phosphorylates CDC25B on multiple sites including S169, S323, S353 and S375, while p38SAPK phosphorylates CDC25B on S249. PMID: 16861915
- Results show under normal cell cycle conditions and in the absence of DNA damage, CDC25B is constitutively phosphorylated by CHK1 during interphase and thus prevents the premature initiation of mitosis. PMID: 17003105
- Chk1 functions to coordinate mitotic events through regulation of Cdc25B PMID: 17106257
- The expression of CDC25B in different cellular compartments of human spermatozoa suggests that there are diverse noncell-cycle-related functions of CDC25B in terminally differentiated human germ cells. PMID: 17336969
- p38 regulates the timing of mitotic entry via modulation of Cdc25B activity under normal nonstress conditions PMID: 17548358
- Cdc25B, but not Cdc25C, is capable of inhibiting cellular proliferation in a manner dependent upon its catalytic activity PMID: 17591782
- CDC25B splice variants have differential mitotic stabilities, a feature that is likely to have major consequences on the local control of cyclin-dependent kinase-cyclin activities during mitotic progression. PMID: 17599046
顯示更多
收起更多
-
亞細胞定位:Cytoplasm, cytoskeleton, microtubule organizing center, centrosome. Cytoplasm, cytoskeleton, spindle pole.
-
蛋白家族:MPI phosphatase family
-
數(shù)據(jù)庫鏈接:
Most popular with customers
-
-
YWHAB Recombinant Monoclonal Antibody
Applications: ELISA, WB, IHC, IF, FC
Species Reactivity: Human, Mouse, Rat
-
Phospho-YAP1 (S127) Recombinant Monoclonal Antibody
Applications: ELISA, WB, IHC
Species Reactivity: Human
-
-
-
-
-